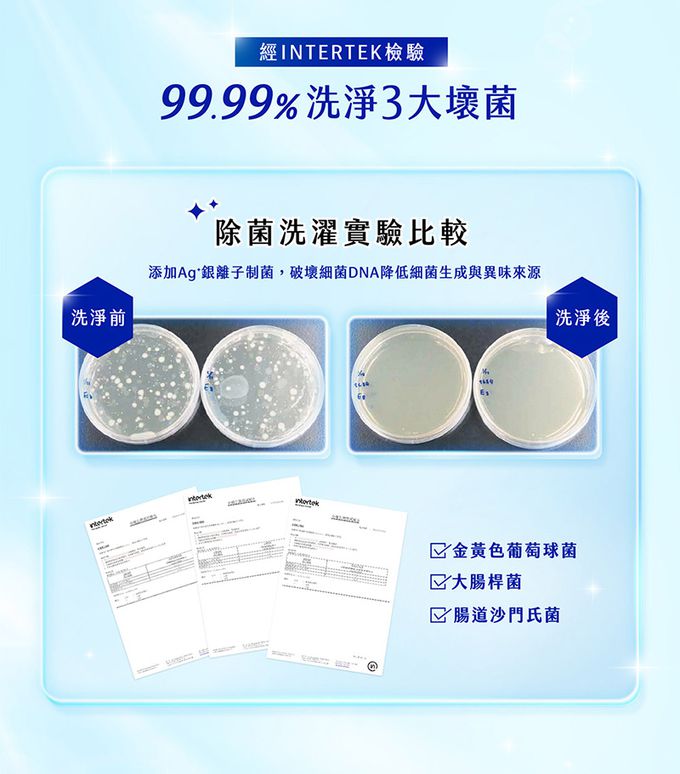
毛寶 maobao - 葳香魔法去污抗菌素-500g

首載 App 現領 $ 100 折價券
 ( 10000+ )
( 10000+ )
1/1
商品特色
實驗證實 有效洗淨4大病毒
特濃天然活性潔淨 迅效潔淨與去味
99.9%抗菌力 抑制異味生成
酵素強力洗淨 深層瓦解特殊汚垢
無添加螢光增白劑、壬基苯酚等有害化學物質

口碑嚴選

正品保證

加密付款

7天鑑賞
付款
信用卡・LINE Pay・街口支付・先享後付・ATM・貨到付款
配送
宅配
免運
超商取貨
免運
註冊新會員立即領首購免運券
介紹

看更多

